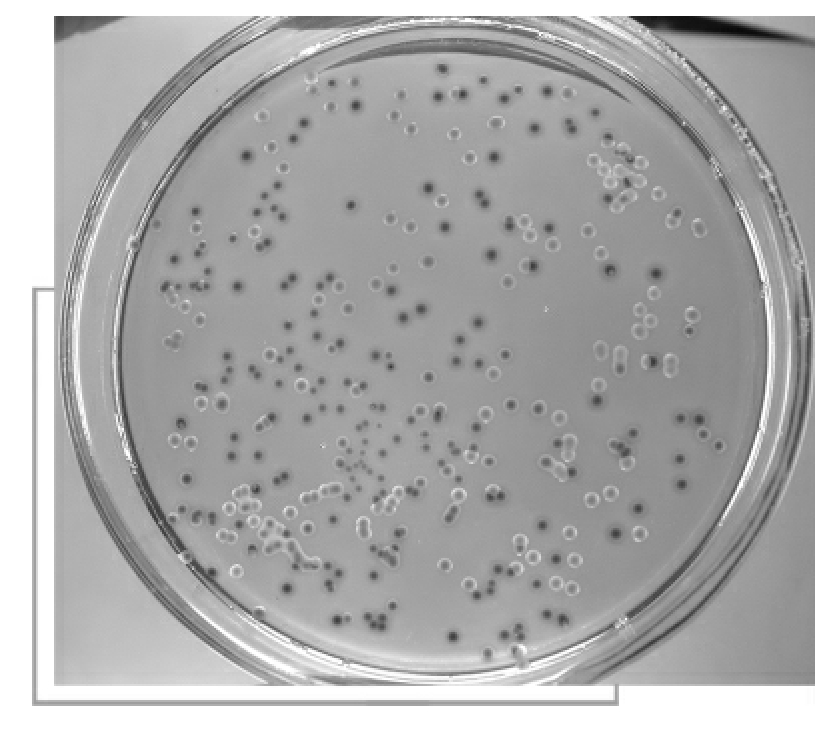
img18

-
1.1前 言
-
1.2走进细菌的世界
-
1.2.1认识微生物
-
1.2.2细菌的形状和种类
-
1.2.3细菌的结构
-
1.2.4细菌的生活
-
1.2.5细菌的繁殖
-
1.2.6细菌的变异
-
1.2.7细菌的食物来源
-
1.2.8无所不在的细菌
-
1.2.9细菌喜欢的场所
-
1.2.10生物因素对细菌的影响
-
1.2.11细菌的致病性
-
1.2.12人体的抗菌与免疫
-
1.3艰难的跋涉
-
1.3.1他看到了一个奇妙的世界
-
1.3.2发现细菌世界的利器
-
1.3.3日新月异的细菌观察诊断技术
-
1.3.4细菌的人工培养
-
1.3.5李斯特和消毒杀菌法
-
1.3.6物理消毒灭菌法
-
1.3.7化学消毒法
-
1.3.8“罐头”与细菌
-
1.3.9奇妙的噬菌体
-
1.3.10梅契尼科夫和吞噬细胞
-
1.4征服致病细菌的荆棘之路
-
1.4.1发现恐怖的炭疽杆菌
-
1.4.2巴斯德和炭疽疫苗
-
1.4.3征服炭疽杆菌的脚步
-
1.4.4屡屡发生的鼠疫大流行
-
1.4.5亚历山大·叶尔辛的功绩
-
1.4.6我国的抗鼠疫英雄——伍连德
-
1.4.7征服鼠疫杆菌的光明前景
-
1.4.8致命的痢疾杆菌
-
1.4.9屡造事端的霍乱
-
1.4.10斯诺与布劳德水井
-
1.4.11科学对待霍乱杆菌
-
1.4.12中国的抗击霍乱之路
-
1.4.13斩断百日咳杆菌蔓延的魔爪
-
1.4.14葡萄球菌与青霉素
-
1.4.15向麻风杆菌宣战
-
1.4.16科赫发现结核杆菌
-
1.4.17卡密特的贡献
-
1.4.18卡介苗的发明
-
1.4.19卡介苗的曲折之路
-
1.4.20抗击结核病的勇士——王良
-
1.4.21结核性疾病的克星——链霉素
-
1.5造福人类的“天使”
-
1.5.1专门吃汞的细菌
-
1.5.2细菌也可做饲料
-
1.5.3密不可分的细菌和农业生产
-
1.5.4无菌不成醋
-
1.5.5甲烷细菌与沼气
-
1.5.6光合细菌造福人类
-
1.5.7细菌冶金
-
1.5.8人类的新助手
-
1.6征服细菌的双刃剑
-
1.6.1黯淡收场的磺胺
-
1.6.2“道高一尺,魔高一丈”——抗生素与细菌的战斗
-
1.6.3“谈之色变”的细菌武器
-
1.6.4罪行累累的“黑太阳”